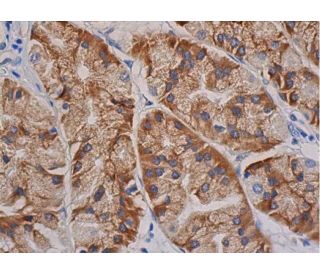
immunohistochemistry image from recommended FAK (D-1) monoclonal antibody replacement. Image 352997

Alexa Fluor® é uma marca comercial da Molecular Probes Inc., OR., EUA
Informacoes sobre ordens
FAK (D-1): sc-271126 [ anticorpo monoclonal substituto recomendado para FAK (A-17) ]
| Nome do Produto | Numero de Catalogo | UNID | Preco | Qde | FAVORITOS | |
FAK Anticorpo (D-1) | sc-271126 | 200 µg/ml | $322.00 | |||
Pacote do FAK (D-1): m-IgG Fc BP-HRP | sc-527208 | 200 µg Ab; 10 µg BP | $361.00 | |||
Pacote do FAK (D-1): m-IgG1 BP-HRP | sc-532581 | 200 µg Ab; 20 µg BP | $361.00 | |||
FAK Anticorpo (D-1) AC | sc-271126 AC | 500 µg/ml, 25% agarose | $424.00 | |||
FAK Anticorpo (D-1) HRP | sc-271126 HRP | 200 µg/ml | $322.00 | |||
FAK Anticorpo (D-1) FITC | sc-271126 FITC | 200 µg/ml | $336.00 | |||
FAK Anticorpo (D-1) PE | sc-271126 PE | 200 µg/ml | $349.00 | |||
FAK Anticorpo (D-1) Alexa Fluor® 488 | sc-271126 AF488 | 200 µg/ml | $364.00 | |||
FAK Anticorpo (D-1) Alexa Fluor® 546 | sc-271126 AF546 | 200 µg/ml | $364.00 | |||
FAK Anticorpo (D-1) Alexa Fluor® 594 | sc-271126 AF594 | 200 µg/ml | $364.00 | |||
FAK Anticorpo (D-1) Alexa Fluor® 647 | sc-271126 AF647 | 200 µg/ml | $364.00 | |||
FAK Anticorpo (D-1) Alexa Fluor® 680 | sc-271126 AF680 | 200 µg/ml | $364.00 | |||
FAK Anticorpo (D-1) Alexa Fluor® 790 | sc-271126 AF790 | 200 µg/ml | $364.00 | |||
FAK Anticorpo (D-1) B | sc-271126 B | 200 µg/ml | $326.00 | |||
FAK (D-1) peptídeo neutralizante | sc-271126 P | 100 µg/0.5 ml | $69.00 |